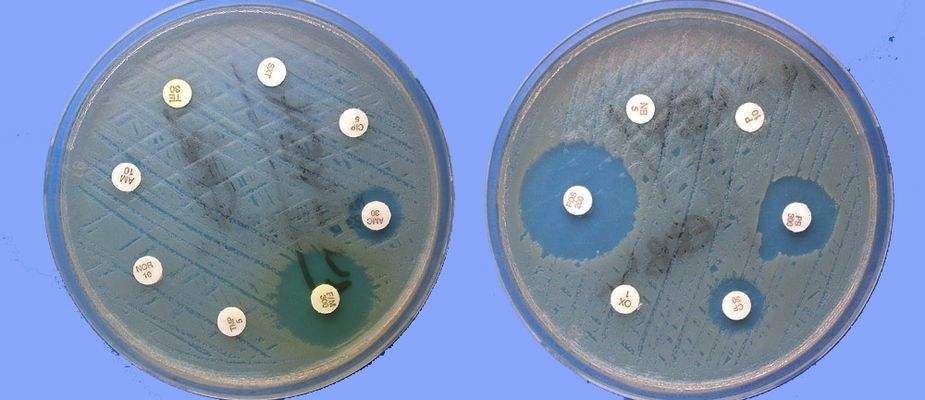

“氟苯尼考”是养猪人再熟悉不过的一种药物,该药是在上世纪八十年代后期研制的一种兽药专用广谱抗生素,属于8大类抗生素中的氯霉素类。该药是美国先灵葆雅公司与1988年研制成功,并在1990年初次在日本上市。因其抗菌谱广泛所以对养猪过程中常见的腹泻和呼吸道疾病都有良好的防治效果。

氟苯尼考属于常见的广谱抗生素,对大多数革兰氏阳性率、革兰氏阴性菌、支原体均敏感。对厌氧革兰氏阳性菌及阴性菌、螺旋体、立克次氏体等均有较强的抗菌作用。相对来说防治革兰氏阴性菌效果优于革兰氏阳性菌。
目前兽药典规定的氟苯尼考适应症为鸡大肠杆菌病及鸭浆膜炎及鱼的杀鲑产生单胞菌、鳗弧菌等,用于敏感细菌所致牛、猪、即肠道感染及支原体引起的慢性呼吸道病。
氟苯尼考的抗菌机理同氯霉素相同,主要同细菌70S核蛋白体的50S亚基上的A位结合,从而抑制肽酰基转移酶,从而抑制肽链的延长,干扰细菌蛋白质的合成而达到抑制细菌生长的目的。

1)氟苯尼考具有胚胎毒性,会对胎儿造成损伤,所以妊娠母猪禁用。
2)氟苯尼考同替米考星、泰乐菌素等大环内酯类抗生素,同林可霉素为代表的林可胺类抗生素抗菌机理(主要同细菌70S核蛋白体的50S亚基上的P位结合,从而抑制肽酰基转移酶,从而抑制肽链的延长)相似,具有竞争性抑制,所以最好不要同时使用。
3)氟苯尼考同奎喏酮类药物、β-内酰胺类药物联用具有拮抗作用,所以临床上氟苯尼考+阿莫西林、氟苯尼考+恩诺沙星等都是不许的搭配方案。
4)氟苯尼考同强力霉素等四环素类药物、新霉素等氨基糖苷类药物以及硫酸粘杆菌素等联用具有协同增效作用。
5)国内育肥猪氟苯尼考的休药期为20天,而美国FDA规定氟苯尼考的停药期为28天,所以建议肥猪出栏前20-28天应该停用,以防药物残留。

氟苯尼考属于广谱抗生素,对临床上常见的腹泻类疾病、呼吸道类疾病等都有良好的防治效果,氟苯尼考具体利用应用方法:
1)三针保健。氟苯尼考属于广谱抗生素,且经过生产工艺的改变可以制成半衰期比较长的药物,适合作为三针保健药物使用,可用于1日龄、7日龄和21日龄保健。
2)仔猪断奶后保健。仔猪断奶后高发断奶后应激性腹泻,和副猪嗜血杆菌、传染性胸膜肺炎等细菌性疾病,可在仔猪断奶后饲料中加入氟苯尼考+强力霉素,连用7-10天预防各种细菌性疾病。
3)预防肥猪支原体感染。支原体属于肥猪常见疾病,主要引起肥猪咳嗽,生长速度放缓,延长出栏时间等问题。因为支原体对氟苯尼考敏感,临床上可在往期猪群咳嗽的高发日龄前使用氟苯尼考7-10天进行支原体的预防。
4)预防母猪产后炎症。氟苯尼考具有胚胎毒性,所以不适合妊娠母猪长时间使用,但可在母猪产后饲料中添加氟苯尼考或母猪产后肌注氟苯尼考注射液,进行子宫炎、乳房炎等产后炎症的预防。

目前临床上氟苯尼考具有注射液、粉剂等剂型,可肌注给药,也可饮水给药和拌料给药,但是需要注意不同给药途径的用药剂量和给药时间有所不同。
1)肌注给药。氟苯尼考一般按照20mg/kg体重肌注给药,每隔48小时给药一次,一般连用不超过2次。
2)拌料给药。以氟苯尼考记,每公斤饲料添加60-100毫克,一般连用5-7天即可;
3)饮水给药。以氟苯尼考记,每升饮水中添加氟苯尼考30-50毫克,连用5-7天。






